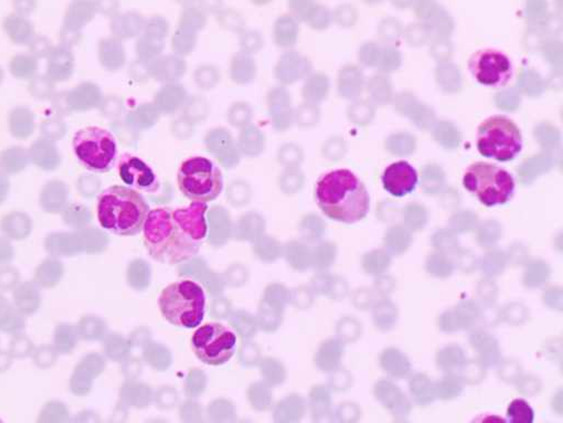

【检验临床面对面】幼儿高嗜酸粒细胞增多症一例
作者:张新丽,周口市中心医院
高嗜酸粒细胞增多症(Hypereosinophilia, HE):外周血2次检查(间隔时间>1个月)嗜酸粒细胞绝对计数>1.5×10^9/L和(或)骨髓有核细胞计数嗜酸粒细胞比例≥20%和(或)病理证实组织嗜酸粒细胞广泛浸润和(或)发现嗜酸粒细胞颗粒蛋白显著沉积(在有或没有较明显的组织嗜酸粒细胞浸润情况下)[1]。
案例经过
患儿3岁,以“发热3天,发现白细胞数增高6小时”为主诉来门诊就诊。血常规检查显示 嗜酸粒细胞数量明显增多,门诊医生收治入院。
既往史
生长发育迟缓,3月龄时在外院诊断为“脑损伤综合征”,进行半年康复治疗。平素易患“呼吸道感染”。1岁翻身,2岁8月能独走,目前大小便不能自理,不会说话。
体格检查
发育落后,营养差,神志清晰,精神稍差。全身皮肤粘膜无黄染、皮疹、出血点,颈部可触及多个淋巴结,质软,活动度可。肝脾肋缘下未触及。
实验室检查







外周血涂片:嗜酸粒细胞占68%,以成熟嗜酸粒细胞为主。(见下图)

骨髓涂片:嗜酸粒细胞占47.2%, 其中嗜酸中幼粒细胞占10.4%,嗜酸晚幼粒细胞占11.2%,嗜酸杆状核粒细胞占13.2%,嗜酸分叶核粒细胞占12.4%。(见下图)



治疗
抗感染治疗无效,嗜酸粒细胞数量不降反升,后调整方案,口服泼尼松,2天(8月11日)后嗜酸粒细胞数量有所下降(见下表),但患儿家属要求出院,院外口服药物治疗。

案例分析
HE分为遗传性HE(HEFA)、继发性HE(HER)、克隆性HE(HEN)和特发性HE(HEUS)四大类,根据外周血嗜酸粒细胞数量分为轻(0.5×10^9-1.5×10^9)、中(1.5×10^9-5×10^9)、重(>5×10^9)三型。
HEFA发病机制不明,呈家族聚集;HER可见于过敏性疾病、皮肤病(非过敏性)、药物、感染性疾病、胃肠道疾病、脉管炎、风湿病、呼吸道疾病、肿瘤等;HEN是指嗜酸粒细胞起源于血液肿瘤克隆。主要包括髓系和淋系肿瘤伴 PDGFRA、 PDGFRB、FGFR1重排或PCM1-JAK2、ETV6-JAK2 或BCR-JAK2融合基因、慢性嗜酸粒细胞白血病-不另作特殊分类(CEL-NOS)、不典型慢性髓性白血病伴嗜酸粒细胞增多(aCML-Eo)、慢性粒单核细胞白血病伴嗜酸粒细胞增多 (CMML-Eo)、慢性髓性白血病加速期或急变期 (偶见)、急性髓系白血病伴嗜酸粒细胞增多(AML-Eo)、急性淋巴细胞白血病等;HEUS是排除性诊断,查不到原发和继发原因[1]。
HE常伴有组织器官功能的受损,需通过仔细询问病史、查体以及相关实验室检查,明确导致嗜酸粒细胞增多症的可能原因,并评价可能的嗜酸粒细胞相关终末器官受损或功能异常。由于HE所涉及病因的复杂性,使临床工作变得繁琐而困难。患儿家属拒绝进一步的检查,所以未找到导致该患儿嗜酸粒细胞增多的原因。该患儿抗感染治疗后症状未得到改善,临床医生尝试性按照特发性高嗜酸粒细胞增多症处理,选择泼尼松口服,2天后嗜酸粒细胞数量有所下降,但是患儿家属强烈要求出院,我们未进行随访,目前不知道患儿的具体情况。
目前,HER的治疗主要是以治疗原发病为主,HEN的治疗药物首选伊马替尼,HEUS的一线治疗首选泼尼松,二线药物有伊马替尼、干扰素、环孢素、硫唑嘌呤等。反复治疗无效时考虑造血干细胞移植。无论是哪种治疗方法,其目的都是降低嗜酸粒细胞计数和减少嗜酸粒细胞介导的器官功能受损。
总结
作为临床工作者,我们遇到类似病例时,不可贸然下结论,要想查找病因,详细的辅助检查是必不可少的。高嗜酸粒细胞增多症病因多样且复杂,未来如何更好地整合现有的医学条件,经济有效地给予明确诊断,对于我们来说是一个巨大的挑战。
参考文献
[1]中华医学会血液学分会白血病淋巴瘤学组.嗜酸粒细胞增多症诊断与治疗中国专家共识(2017年版)[J].中华血液学杂志,2017,(7):561-565.

